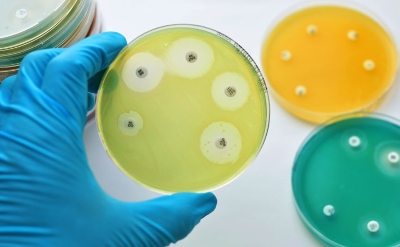

Treatment with zanubrutinib led to significant improvements in progression-free survival when compared with ibrutinib in a cohort of patients with relapsed or refractory chronic lymphocytic leukemia, according to phase 3 study results published in...

Nearly all patients with recalcitrant cutaneous dermatomyositis who used apremilast as an add-on therapy showed a response to treatment after 3 months, according to recent research published in...

Autologous platelet-rich plasma (PRP) appears to help improve terminal hair density, but not hair thickness, in women with androgenetic alopecia, according to a recent...

The addition of serplulimab to chemotherapy significantly improved overall survival outcomes compared to chemotherapy alone in patients with previously untreated extensive-stage small cell lung cancer, according to...

Genetic variation in IL7 expression may be linked to increased immune-related adverse events in patients receiving immune checkpoint blockade for melanoma, according to research published in...
By Jennifer Rigby, Natalie Grover and Maggie Fick LONDON/KISUMU, Kenya, July 13 (Reuters) - After decades of work, the World Health Organization endorsed the first-ever malaria vaccine last year - a Read More »